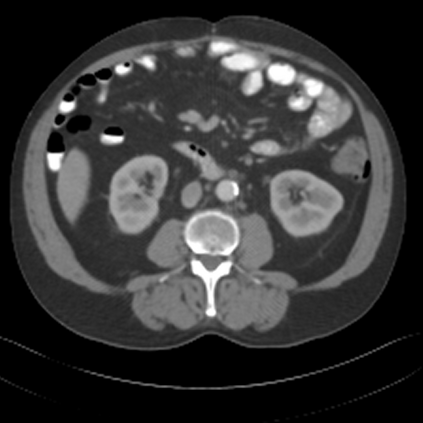

Sparse-view computed tomography (CT) -- using a small number of projections for tomographic reconstruction -- enables much lower radiation dose to patients and accelerated data acquisition. The reconstructed images, however, suffer from strong artifacts, greatly limiting their diagnostic value. Current trends for sparse-view CT turn to the raw data for better information recovery. The resultant dual-domain methods, nonetheless, suffer from secondary artifacts, especially in ultra-sparse view scenarios, and their generalization to other scanners/protocols is greatly limited. A crucial question arises: have the image post-processing methods reached the limit? Our answer is not yet. In this paper, we stick to image post-processing methods due to great flexibility and propose global representation (GloRe) distillation framework for sparse-view CT, termed GloReDi. First, we propose to learn GloRe with Fourier convolution, so each element in GloRe has an image-wide receptive field. Second, unlike methods that only use the full-view images for supervision, we propose to distill GloRe from intermediate-view reconstructed images that are readily available but not explored in previous literature. The success of GloRe distillation is attributed to two key components: representation directional distillation to align the GloRe directions, and band-pass-specific contrastive distillation to gain clinically important details. Extensive experiments demonstrate the superiority of the proposed GloReDi over the state-of-the-art methods, including dual-domain ones. The source code is available at https://github.com/longzilicart/GloReDi.
翻译:暂无翻译